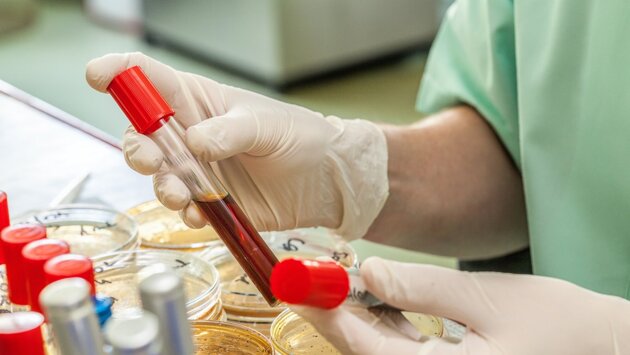

Ученые выяснили, чем уникальна вторая группа крови
В результате эволюции у людей сформировалось четыре группы крови, и состав каждой из них отличается друг от друга. По мнению учёных, группа крови может даже оказывать влияние на как на физиологические, так и психологические особенности человека.
Отмечается, что у людей с группой крови II(А) в организме больше, чем у других, вырабатывается кортизол – гормон, защищающий от стресса. Также он регулирует артериальное давление, уровень глюкозы и всю работу иммунной системы. При этом избыток кортизола может приводить к мгновенной реакции на стресс. В результате эти люди подвержены состоянию хронического стресса, а также нарушается сон и возникает лишний вес.
Кроме того, американские ученые Онкоинститута Даны Фарбера обнаружили еще одну особенность. У представителей II группы крови оказался выше риск онкологических заболеваний: они чаще страдают острым лейкозом и раком желудка. В то же время среди людей с данной группой крови много долгожителей.